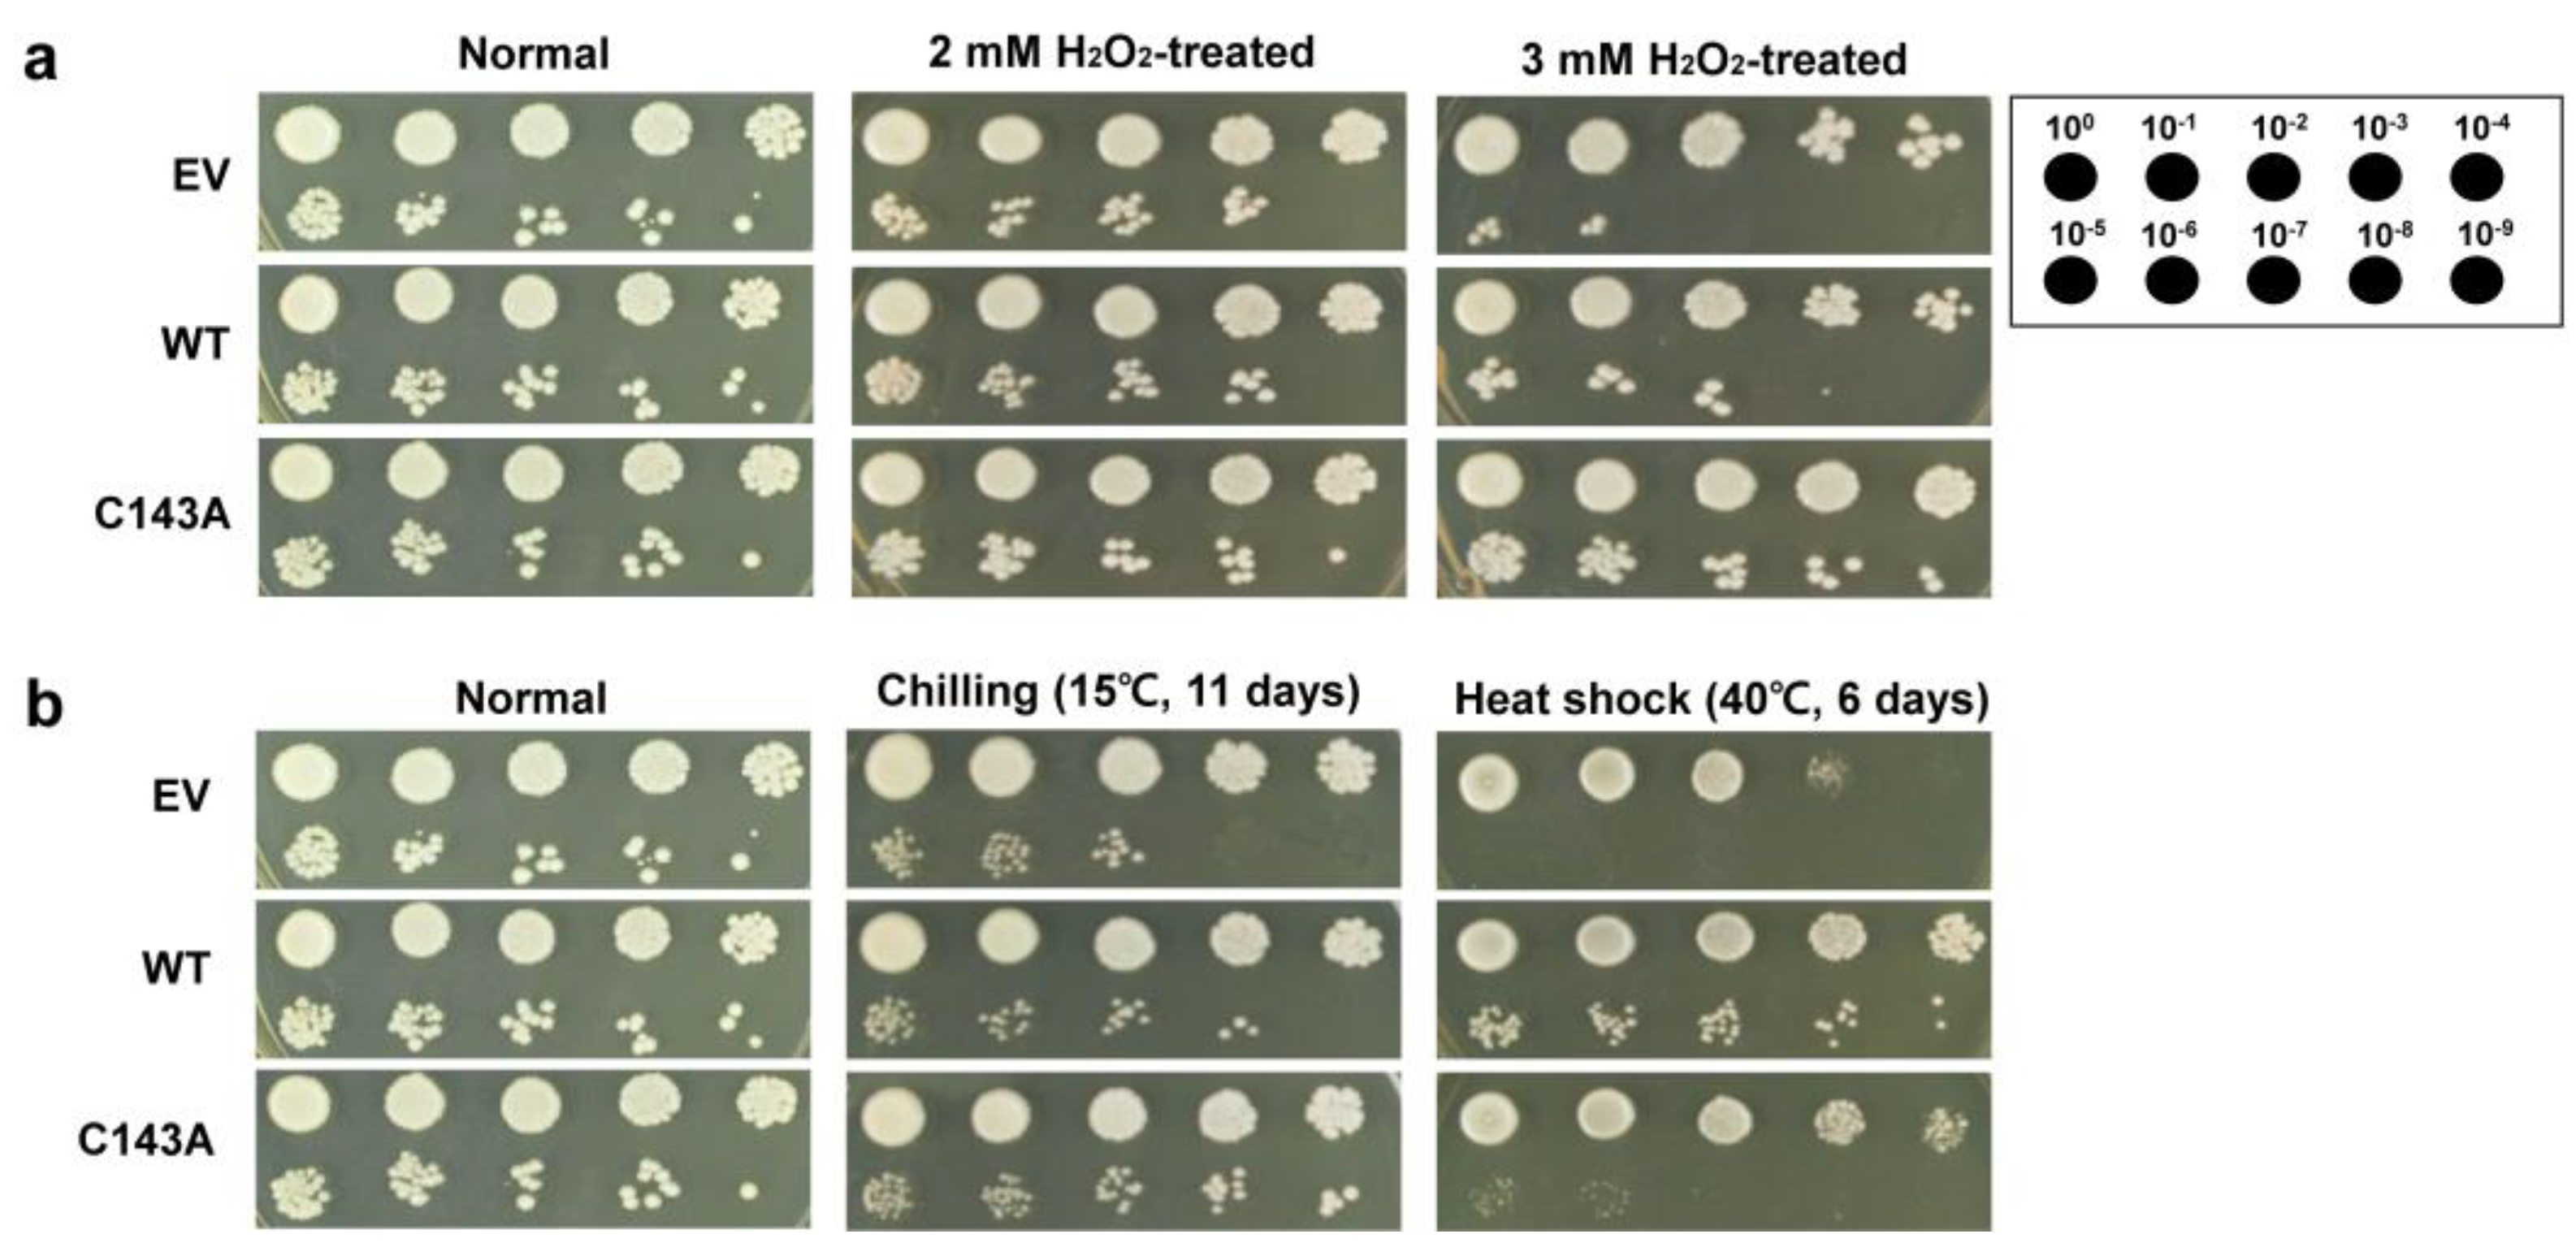
Molecules 27 02934 g004 550

Investigating the Functional Role of the Cysteine Residue in Dehydrin from the Arctic Mouse-Ear Chickweed Cerastium arcticum
Abstract
:1. Introduction
2. Results & Discussion
2.1. Disulfide Bond-Mediated Dimerization
2.2. Metal Binding Activity (MBA)
2.3. Yeast Stress Tolerance Assay
3. Materials and Methods
3.1. Cloning, Expression and Purification
3.2. Native Gel Electrophoresis
3.3. Development of Yeast Expression Vector and Transgenic Yeast
3.4. Stress Response Assay in Yeast Cells
Supplementary Materials
Author Contributions
Funding
Data Availability Statement
Conflicts of Interest
References
- Hagen, A.R.; Giese, H.; Brochmann, C. Trans-Atlantic dispersal and phylogeography of Cerastium arcticum (Caryophyllaceae) inferred from RAPD and SCAR markers. Am. J. Bot. 2001, 88, 103–112. [Google Scholar] [CrossRef] [PubMed]
- Bokhorst, S.; Bjerke, J.W.; Davey, M.P.; Taulavuori, K.; Taulavuori, E.; Laine, K.; Callaghan, T.V.; Phoenix, G.K. Impacts of extreme winter warming events on plant physiology in a sub-Arctic heath community. Physiol. Plant. 2010, 140, 128–140. [Google Scholar] [CrossRef] [PubMed]
- Chew, O.; Lelean, S.; John, U.P.; Spangenberg, G.C. Cold acclimation induces rapid and dynamic changes in freeze tolerance mechanisms in the cryophile Deschampsia antarctica E. Desv. Plant Cell Environ. 2012, 35, 829–837. [Google Scholar] [CrossRef]
- Archambault, A.; Stromvik, M.V. PR-10, defensin and cold dehydrin genes are among those over expressed in Oxytropis (Fabaceae) species adapted to the arctic. Funct. Integr. Genomics 2011, 11, 497–505. [Google Scholar] [CrossRef] [PubMed] [Green Version]
- Allagulova, C.R.; Gimalov, F.R.; Shakirova, F.M.; Vakhitov, V.A. The plant dehydrins: Structure and putative functions. Biochemistry 2003, 68, 945–951. [Google Scholar] [PubMed]
- Garay-Arroyo, A.; Colmenero-Flores, J.M.; Garciarrubio, A.; Covarrubias, A.A. Highly hydrophilic proteins in prokaryotes and eukaryotes are common during conditions of water deficit. J. Biol. Chem. 2000, 275, 5668–5674. [Google Scholar] [CrossRef] [PubMed] [Green Version]
- Singh, S.; Cornilescu, C.C.; Tyler, R.C.; Cornilescu, G.; Tonelli, M.; Lee, M.S.; Markley, J.L. Solution structure of a late embryogenesis abundant protein (LEA14) from Arabidopsis thaliana, a cellular stress-related protein. Protein Sci. 2005, 14, 2601–2609. [Google Scholar] [CrossRef] [PubMed] [Green Version]
- Babu, R.C.; Zhang, J.X.; Blum, A.; Ho, T.H.D.; Wu, R.; Nguyen, H.T. HVA1, a LEA gene from barley confers dehydration tolerance in transgenic rice (Oryza sativa L.) via cell membrane protection. Plant Sci. 2004, 166, 855–862. [Google Scholar] [CrossRef]
- Kim, H.S.; Lee, J.H.; Kim, J.J.; Kim, C.H.; Jun, S.S.; Hong, Y.N. Molecular and functional characterization of CaLEA6, the gene for a hydrophobic LEA protein from Capsicum annuum. Gene 2005, 344, 115–123. [Google Scholar] [CrossRef]
- Sasaki, K.; Christov, N.K.; Tsuda, S.; Imai, R. Identification of a novel LEA protein involved in freezing tolerance in wheat. Plant Cell Physiol. 2014, 55, 136–147. [Google Scholar] [CrossRef] [PubMed] [Green Version]
- Dure, L.; Crouch, M.; Harada, J.; Ho, T.H.D.; Mundy, J.; Quatrano, R.; Thomas, T.; Sung, Z.R. Common amino-acid sequence domains among the LEA proteins of higher plants. Plant Mol. Biol. 1989, 12, 475–486. [Google Scholar] [CrossRef] [PubMed]
- Close, T.J. Dehydrins: A commonality in the response of plants to dehydration and low temperature. Physiol. Plant. 1997, 100, 291–296. [Google Scholar] [CrossRef]
- Yang, Y.; He, M.; Zhu, Z.; Li, S.; Xu, Y.; Zhang, C.; Singer, S.D.; Wang, Y. Identification of the dehydrin gene family from grapevine species and analysis of their responsiveness to various forms of abiotic and biotic stress. BMC Plant Biol. 2012, 12, 140. [Google Scholar] [CrossRef] [PubMed] [Green Version]
- Takahashi, R.; Joshee, N.; Kitagawa, Y. Induction of chilling resistance by water-stress, and cDNA sequence-analysis and expression of water stress-regulated genes in rice. Plant Mol. Biol. 1994, 26, 339–352. [Google Scholar] [CrossRef] [PubMed]
- Campbell, S.A.; Close, T.J. Dehydrins: Genes, proteins, and associations with phenotypic traits. New Phytol. 1997, 137, 61–74. [Google Scholar] [CrossRef]
- Koag, M.C.; Wilkens, S.; Fenton, R.D.; Resnik, J.; Vo, E.; Close, T.J. The K-segment of maize DHN1 mediates binding to anionic phospholipid vesicles and concomitant structural changes. Plant Physiol. 2009, 150, 1503–1514. [Google Scholar] [CrossRef] [PubMed] [Green Version]
- Hughes, S.; Graether, S.P. Cryoprotective mechanism of a small intrinsically disordered dehydrin protein. Protein Sci. 2011, 20, 42–50. [Google Scholar] [CrossRef] [Green Version]
- Alsheikh, M.K.; Svensson, J.T.; Randall, S.K. Phosphorylation regulated ion-binding is a property shared by the acidic subclass dehydrins. Plant Cell Environ. 2005, 28, 1114–1122. [Google Scholar] [CrossRef]
- Close, T.J. Dehydrins: Emergence of a biochemical role of a family of plant dehydration proteins. Physiol. Plant. 1996, 97, 795–803. [Google Scholar] [CrossRef]
- Kim, I.S.; Kim, H.Y.; Kim, Y.S.; Choi, H.G.; Kang, S.H.; Yoon, H.S. Expression of dehydrin gene from Arctic Cerastium arcticum increases abiotic stress tolerance and enhances the fermentation capacity of a genetically engineered Saccharomyces cerevisiae laboratory strain. Appl. Microbiol. Biotechnol. 2013, 97, 8997–9009. [Google Scholar] [CrossRef]
- Graether, S.P.; Boddington, K.F. Disorder and function: A review of the dehydrin protein family. Front. Plant Sci. 2014, 5, 576. [Google Scholar] [CrossRef] [Green Version]
- Lumb, I.; Hundal, M.S.; Hundal, G. Copper(II)-catalyzed disulfide scission--stepwise aerobic oxidative cleavage to sulfinate and sulfonate and reductive anaerobic cleavage to thiols. Inorg. Chem. 2014, 53, 7770–7779. [Google Scholar] [CrossRef]
- Hiniker, A.; Collet, J.F.; Bardwell, J.C. Copper stress causes an in vivo requirement for the Escherichia coli disulfide isomerase DsbC. J. Biol. Chem. 2005, 280, 33785–33791. [Google Scholar] [CrossRef] [Green Version]
- Hernandez-Sanchez, I.E.; Martynowicz, D.M.; Rodriguez-Hernandez, A.A.; Perez-Morales, M.B.; Graether, S.P.; Jimenez-Bremont, J.F. A dehydrin-dehydrin interaction: The case of SK3 from Opuntia streptacantha. Front. Plant Sci. 2014, 5, 520. [Google Scholar] [CrossRef]
- Hara, M.; Kondo, M.; Kato, T. A KS-type dehydrin and its related domains reduce Cu-promoted radical generation and the histidine residues contribute to the radical-reducing activities. J. Exp. Bot. 2013, 64, 1615–1624. [Google Scholar] [CrossRef] [Green Version]
- Mu, P.Q.; Feng, D.R.; Su, J.B.; Zhang, Y.; Dai, J.R.; Jin, H.L.; Liu, B.; He, Y.M.; Qi, K.B.; Wang, H.B.; et al. Cu2+ triggers reversible aggregation of a disordered His-rich dehydrin MpDhn12 from Musa paradisiaca. J. Biochem. 2011, 150, 491–499. [Google Scholar] [CrossRef]
- Hara, M.; Fujinaga, M.; Kuboi, T. Metal binding by citrus dehydrin with histidine-rich domains. J. Exp. Bot. 2005, 56, 2695–2703. [Google Scholar] [CrossRef] [Green Version]
- Rahman, L.N.; McKay, F.; Giuliani, M.; Quirk, A.; Moffatt, B.A.; Harauz, G.; Dutcher, J.R. Interactions of Thellungiella salsuginea dehydrins TsDHN-1 and TsDHN-2 with membranes at cold and ambient temperatures-surface morphology and single-molecule force measurements show phase separation, and reveal tertiary and quaternary associations. Biochim. Biophys. Acta 2013, 1828, 967–980. [Google Scholar] [CrossRef] [Green Version]
- Alsheikh, M.K.; Heyen, B.J.; Randall, S.K. Ion binding properties of the dehydrin ERD14 are dependent upon phosphorylation. J. Biol. Chem. 2003, 278, 40882–40889. [Google Scholar] [CrossRef] [Green Version]
- Kruger, C.; Berkowitz, O.; Stephan, U.W.; Hell, R. A metal-binding member of the late embryogenesis abundant protein family transports iron in the phloem of Ricinus communis L. J. Biol. Chem. 2002, 277, 25062–25069. [Google Scholar] [CrossRef] [Green Version]
- Svensson, J.; Palva, E.T.; Welin, B. Purification of recombinant Arabidopsis thaliana dehydrins by metal ion affinity chromatography. Protein Expr. Purif. 2000, 20, 169–178. [Google Scholar] [CrossRef] [PubMed]
- Xu, J.; Zhang, Y.X.; Wei, W.; Han, L.; Guan, Z.Q.; Wang, Z.; Chai, T.Y. BjDHNs confer heavy-metal tolerance in plants. Mol. Biotechnol. 2008, 38, 91–98. [Google Scholar] [CrossRef] [PubMed]
- Waszczak, C.; Akter, S.; Jacques, S.; Huang, J.J.; Messens, J.; Van Breusegem, F. Oxidative post-translational modifications of cysteine residues in plant signal transduction. J. Exp. Bot. 2015, 66, 2923–2934. [Google Scholar] [CrossRef] [PubMed] [Green Version]
- Hanin, M.; Brini, F.; Ebel, C.; Toda, Y.; Takeda, S.; Masmoudi, K. Plant dehydrins and stress tolerance: Versatile proteins for complex mechanisms. Plant Signal. Behav. 2011, 6, 1503–1509. [Google Scholar] [CrossRef]
- Mouillon, J.M.; Eriksson, S.K.; Harryson, P. Mimicking the plant cell interior under water stress by macromolecular crowding: Disordered dehydrin proteins are highly resistant to structural collapse. Plant Physiol. 2008, 148, 1925–1937. [Google Scholar] [CrossRef] [Green Version]
- Puhakainen, T.; Hess, M.W.; Makela, P.; Svensson, J.; Heino, P.; Palva, E.T. Overexpression of multiple dehydrin genes enhances tolerance to freezing stress in Arabidopsis. Plant Mol. Biol. 2004, 54, 743–753. [Google Scholar] [CrossRef]
- Rorat, T. Plant dehydrins--tissue location, structure and function. Cell. Mol. Biol. Lett. 2006, 11, 536–556. [Google Scholar] [CrossRef]
- Hara, M.; Terashima, S.; Fukaya, T.; Kuboi, T. Enhancement of cold tolerance and inhibition of lipid peroxidation by citrus dehydrin in transgenic tobacco. Planta 2003, 217, 290–298. [Google Scholar] [CrossRef]
- Gietz, R.D.; Woods, R.A. Genetic transformation of yeast. Biotechniques 2001, 30, 816–820, 822–826, 828 passim. [Google Scholar] [CrossRef] [Green Version]
- Hara, M.; Shinoda, Y.; Tanaka, Y.; Kuboi, T. DNA binding of citrus dehydrin promoted by zinc ion. Plant Cell Environ. 2009, 32, 532–541. [Google Scholar] [CrossRef]

Publisher’s Note: MDPI stays neutral with regard to jurisdictional claims in published maps and institutional affiliations. |
© 2022 by the authors. Licensee MDPI, Basel, Switzerland. This article is an open access article distributed under the terms and conditions of the Creative Commons Attribution (CC BY) license (https://creativecommons.org/licenses/by/4.0/).
Share and Cite
Kim, I.-S.; Choi, W.; Park, A.K.; Kim, H.; Son, J.; Lee, J.H.; Shin, S.C.; Kim, T.D.; Kim, H.-W. Investigating the Functional Role of the Cysteine Residue in Dehydrin from the Arctic Mouse-Ear Chickweed Cerastium arcticum. Molecules 2022, 27, 2934. https://doi.org/10.3390/molecules27092934
Kim I-S, Choi W, Park AK, Kim H, Son J, Lee JH, Shin SC, Kim TD, Kim H-W. Investigating the Functional Role of the Cysteine Residue in Dehydrin from the Arctic Mouse-Ear Chickweed Cerastium arcticum. Molecules. 2022; 27(9):2934. https://doi.org/10.3390/molecules27092934
Chicago/Turabian StyleKim, Il-Sup, Woong Choi, Ae Kyung Park, Hyun Kim, Jonghyeon Son, Jun Hyuck Lee, Seung Chul Shin, T. Doohun Kim, and Han-Woo Kim. 2022. "Investigating the Functional Role of the Cysteine Residue in Dehydrin from the Arctic Mouse-Ear Chickweed Cerastium arcticum" Molecules 27, no. 9: 2934. https://doi.org/10.3390/molecules27092934
APA StyleKim, I.-S., Choi, W., Park, A. K., Kim, H., Son, J., Lee, J. H., Shin, S. C., Kim, T. D., & Kim, H.-W. (2022). Investigating the Functional Role of the Cysteine Residue in Dehydrin from the Arctic Mouse-Ear Chickweed Cerastium arcticum. Molecules, 27(9), 2934. https://doi.org/10.3390/molecules27092934

